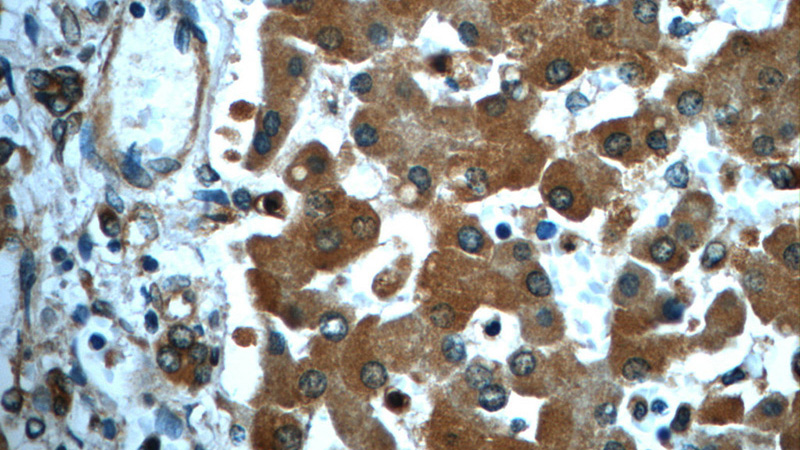
Immunohistochemistry of paraffin-embedded human liver slide using Catalog No:115452(SND1 Antibody) at dilution of 1:50

-
Product Name
SND1 antibody
- Documents
-
Description
SND1 Rabbit Polyclonal antibody. Positive WB detected in HeLa cells, COLO 320 cells, Jurkat cells. Positive IF detected in HeLa cells. Positive IHC detected in human liver tissue. Observed molecular weight by Western-blot: 101 kDa
-
Tested applications
ELISA, WB, IHC, IF
-
Species reactivity
Human,Mouse,Rat; other species not tested.
-
Alternative names
100 kDa coactivator antibody; EBNA2 coactivator p100 antibody; p100 antibody; p100 co activator antibody; SND1 antibody; TDRD11 antibody
-
Isotype
Rabbit IgG
-
Preparation
This antibody was obtained by immunization of SND1 recombinant protein (Accession Number: NM_014390). Purification method: Antigen affinity purified.
-
Clonality
Polyclonal
-
Formulation
PBS with 0.1% sodium azide and 50% glycerol pH 7.3.
-
Storage instructions
Store at -20℃. DO NOT ALIQUOT
-
Applications
Recommended Dilution:
WB: 1:200-1:1000
IHC: 1:20-1:200
IF: 1:50-1:500
-
Validations

HeLa cells were subjected to SDS PAGE followed by western blot with Catalog No:115452(SND1 antibody) at dilution of 1:300
Immunohistochemistry of paraffin-embedded human liver slide using Catalog No:115452(SND1 Antibody) at dilution of 1:50

Immunofluorescent analysis of (-20oc Ethanol) fixed HeLa cells using Catalog No:115452(SND1 Antibody) at dilution of 1:50 and Alexa Fluor 488-congugated AffiniPure Goat Anti-Rabbit IgG(H+L)
-
Background
Staphylococcal nuclease domain-containing 1 (SND1), is a multifunctional nuclease that consists of four staphylococcal nuclease domains and a tudor domain. SND1 acts as a coactivator that facilitates transcriptional activity of STAT5, 6 and c-Myc. SND1 is a comprising part of the RNA-induced silencing complex(RISC), and takes part in the functions of miRNA, regulates transcription through transcriptional coactivation, RNA interference, RNA splicing, and RNA editing. Higher level of SND1 has been found in colon cancer and prostate cancer, can promote HCC angiogenesis in xenograft model through induction of angiogenic factors. This is a rabbit polyclonal antibody raised against near the C-terminus of human SND1.
-
References
- Wang Z, Ni J, Shao D. Elevated transcriptional co-activator p102 mediates angiotensin II type 1 receptor up-regulation and extracellular matrix overproduction in the high glucose-treated rat glomerular mesangial cells and isolated glomeruli. European journal of pharmacology. 702(1-3):208-17. 2013.
- Ho J, Kong JW, Choong LY. Novel breast cancer metastasis-associated proteins. Journal of proteome research. 8(2):583-94. 2009.
Related Products / Services
Please note: All products are "FOR RESEARCH USE ONLY AND ARE NOT INTENDED FOR DIAGNOSTIC OR THERAPEUTIC USE"
